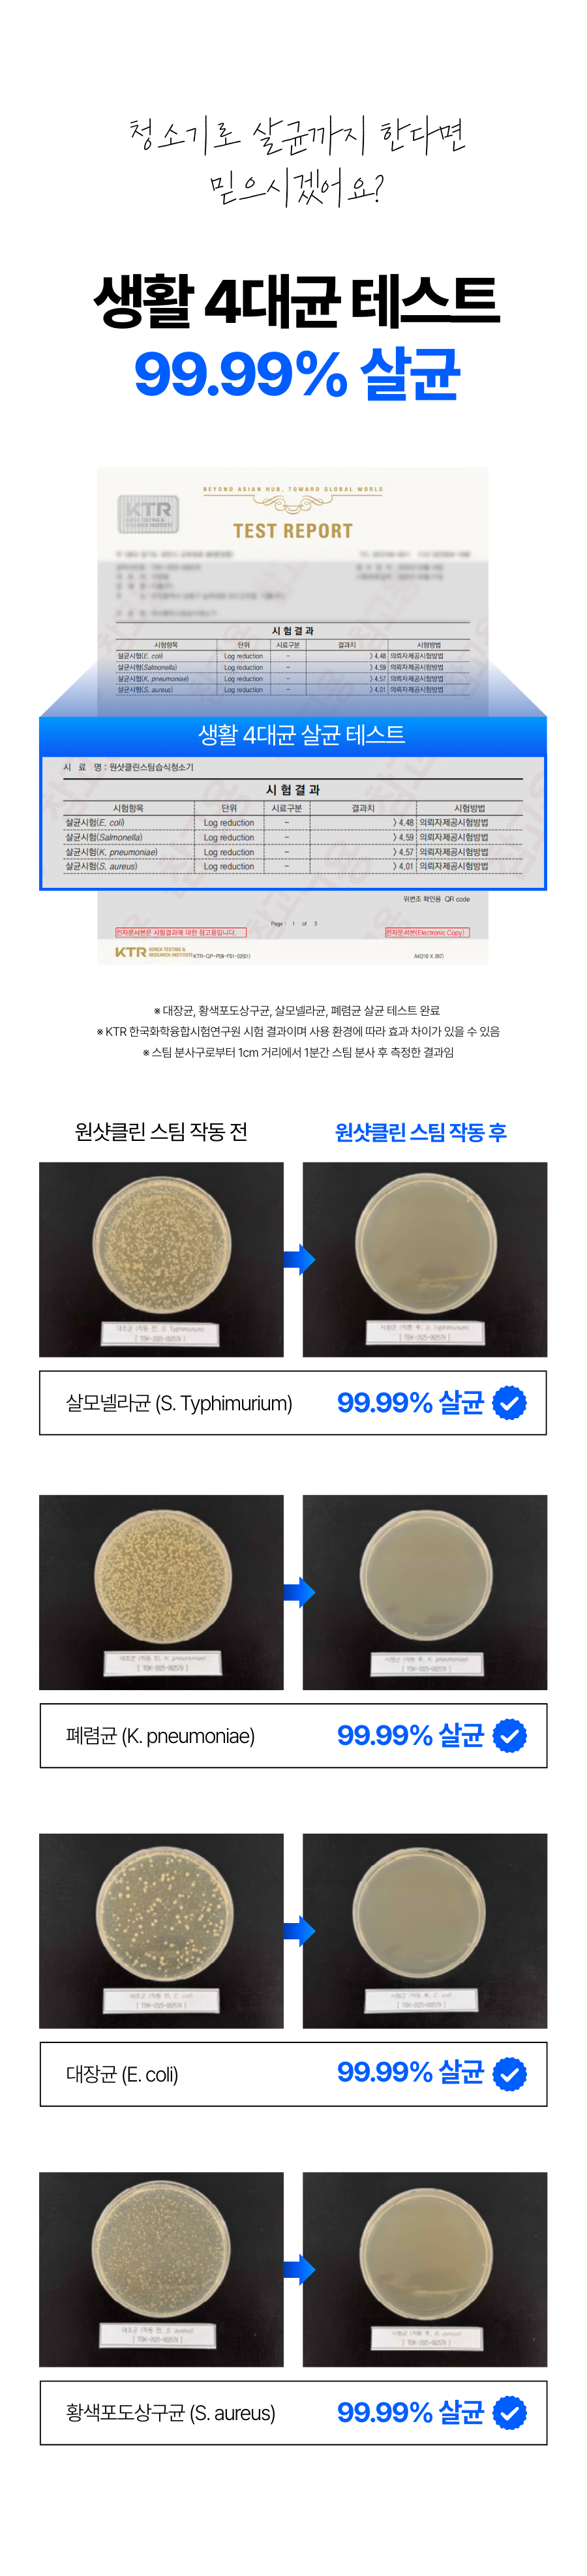

1. 🧼 High-Temperature Steam Wet Cleaner - Removes deep stains and bacteria with 100°C steam and wet cleaning 2. 🛋️ Sofa, Bed, and Car Seat Cleaning - Effectively cleans deep fabric dirt and dust mites in one shot 3. 🎁 Exclusive 58% Discount on Wadiz - Limited quantity launch with bonus cleaning brush and cloth cover
디클(주)
1. 🧼 High-Temperature Steam Wet Cleaner - Removes deep stains and bacteria with 100°C steam and wet cleaning 2. 🛋️ Sofa, Bed, and Car Seat Cleaning - Effectively cleans deep fabric dirt and dust mites in one shot 3. 🎁 Exclusive 58% Discount on Wadiz - Limited quantity launch with bonus cleaning brush and cloth cover